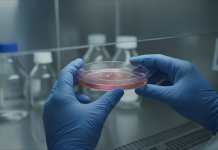
AI malattie rare: come l’intelligenza artificiale risolve il problema AI malattie rare: laboratorio biotecnologico con intelligenza artificiale

L’AI malattie rare sta diventando la chiave per sbloccare migliaia di patologie ancora senza cura. Nonostante gli strumenti moderni per l’editing genetico e la progettazione di farmaci, migliaia di malattie rare rimangono senza trattamento. Secondo i dirigenti di Insilico Medicine e GenEditBio, l’ingrediente mancante è sempre stato trovare abbastanza ricercatori qualificati per portare avanti il lavoro.
Grazie per avere letto questo articolo, non dimenticare di iscriverti al nostro feed!
Come l’AI malattie rare colma il gap di competenze

Inoltre, l’intelligenza artificiale si sta affermando come moltiplicatore di forze che permette agli scienziati di affrontare problemi che l’industria ha a lungo trascurato. Durante il Web Summit Qatar di questa settimana, Alex Aliper, presidente di Insilico, ha illustrato l’obiettivo della sua azienda: sviluppare una “superintelligenza farmaceutica”.
Di conseguenza, Insilico ha recentemente lanciato il suo “MMAI Gym”, che mira ad addestrare modelli linguistici generalisti come ChatGPT e Gemini a performare quanto i modelli specializzati. Nello specifico, l’obiettivo è costruire un modello multimodale e multitasking capace di risolvere simultaneamente diverse attività di scoperta farmacologica con accuratezza sovrumana.
“Abbiamo davvero bisogno di questa tecnologia per aumentare la produttività dell’industria farmaceutica e affrontare la carenza di manodopera e talenti in questo settore”, ha dichiarato Aliper in un’intervista. “Ci sono ancora migliaia di malattie senza cura, senza opzioni terapeutiche, e migliaia di disturbi rari che vengono trascurati. Pertanto, abbiamo bisogno di sistemi più intelligenti per affrontare questo problema.”
L’AI malattie rare nella scoperta di nuovi farmaci
Tuttavia, la piattaforma di Insilico elabora dati biologici, chimici e clinici per generare ipotesi su bersagli terapeutici e molecole candidate. Automatizzando passaggi che un tempo richiedevano legioni di chimici e biologi, l’azienda afferma di poter vagliare vasti spazi di progettazione, nominare candidati terapeutici di alta qualità e persino riutilizzare farmaci esistenti, il tutto a costi e tempi drasticamente ridotti.
Ad esempio, l’azienda ha recentemente utilizzato i suoi modelli AI per identificare se farmaci esistenti potessero essere riutilizzati per trattare la SLA, un raro disturbo neurologico. Allo stesso modo, questo approccio dimostra come l’AI malattie rare possa accelerare la ricerca senza partire da zero ogni volta.
L’editing genetico potenziato dall’intelligenza artificiale
In aggiunta, il collo di bottiglia della manodopera non si ferma alla scoperta di farmaci. Anche quando l’AI può identificare bersagli o terapie promettenti, molte malattie richiedono interventi a un livello biologico più fondamentale. GenEditBio fa parte della “seconda ondata” dell’editing genetico CRISPR, in cui il processo si sposta dall’editing di cellule fuori dal corpo (ex vivo) verso una consegna precisa all’interno del corpo (in vivo).
“Abbiamo sviluppato un ePDV proprietario, o veicolo di consegna proteica ingegnerizzato, ed è una particella simile a un virus”, ha spiegato Tian Zhu, co-fondatrice e CEO di GenEditBio. “Impariamo dalla natura e utilizziamo metodi di machine learning AI per estrarre risorse naturali e scoprire quali tipi di virus hanno affinità con determinati tipi di tessuti.”
La piattaforma NanoGalaxy e i veicoli di consegna
Ciononostante, le “risorse naturali” a cui Zhu si riferisce sono la massiccia libreria di GenEditBio di migliaia di nanoparticelle polimeriche uniche, non virali e non lipidiche. In altre parole, si tratta essenzialmente di veicoli di consegna progettati per trasportare in sicurezza strumenti di editing genetico in cellule specifiche.
L’azienda afferma che la sua piattaforma NanoGalaxy utilizza l’AI per analizzare dati e identificare come le strutture chimiche si correlano con specifici bersagli tissutali (come occhio, fegato o sistema nervoso). Successivamente, l’AI prevede quali modifiche alla chimica di un veicolo di consegna lo aiuteranno a trasportare un carico senza innescare una risposta immunitaria.
GenEditBio testa i suoi ePDV in vivo nei laboratori, e i risultati vengono reinseriti nell’AI per affinare la sua accuratezza predittiva per il ciclo successivo. Una consegna efficiente e tessuto-specifica è un prerequisito per l’editing genetico in vivo, sostiene Zhu. Inoltre, l’azienda ha recentemente ricevuto l’approvazione FDA per iniziare le sperimentazioni di terapia CRISPR per la distrofia corneale.
La sfida persistente dei dati nell’AI malattie rare
Come per molti sistemi basati su AI, il progresso nella biotech si scontra ultimamente con un problema di dati. Modellare i casi limite della biologia umana richiede molti più dati di alta qualità di quanti i ricercatori possano attualmente ottenere.
“Abbiamo ancora bisogno di più dati di verità provenienti dai pazienti”, ha affermato Aliper. “Il corpus di dati è fortemente sbilanciato verso il mondo occidentale, dove viene generato. Penso che abbiamo bisogno di più sforzi locali, per avere un set più equilibrato di dati originali, in modo che i nostri modelli siano anche più capaci di gestirli.”
Aliper ha spiegato che i laboratori automatizzati di Insilico generano dati biologici multi-strato da campioni di malattie su larga scala, senza intervento umano, che poi vengono alimentati nella sua piattaforma di scoperta basata su AI.
I gemelli digitali e le sperimentazioni virtuali
Uno dei prossimi grandi sforzi, secondo Aliper, sarà la costruzione di gemelli digitali degli esseri umani per condurre sperimentazioni cliniche virtuali, un processo che definisce “ancora agli inizi”. Ecco perché la trasformazione digitale in ambito biotech rappresenta una priorità strategica per l’intero settore.
“Siamo su un plateau di circa 50 farmaci approvati dalla FDA ogni anno, e dobbiamo vedere una crescita”, ha dichiarato Aliper. “C’è un aumento dei disturbi cronici perché stiamo invecchiando come popolazione globale. La mia speranza è che tra 10-20 anni avremo più opzioni terapeutiche per il trattamento personalizzato dei pazienti.”
Il futuro dell’AI malattie rare
In definitiva, l’AI malattie rare non è solo una promessa futuristica, ma una realtà operativa che sta già trasformando la ricerca biotech. Le principali innovazioni includono:
- Automazione della scoperta di farmaci attraverso modelli multimodali
- Editing genetico in vivo con veicoli di consegna intelligenti
- Riutilizzo di farmaci esistenti per nuove indicazioni terapeutiche
- Generazione di dati biologici su larga scala senza intervento umano
- Sviluppo di gemelli digitali per sperimentazioni cliniche virtuali
In conclusione, mentre migliaia di malattie rare attendono ancora una cura, l’intelligenza artificiale sta dimostrando di essere lo strumento chiave per superare i limiti umani nella ricerca farmaceutica. Grazie a piattaforme come quelle di Insilico Medicine e GenEditBio, il futuro della medicina personalizzata appare sempre più vicino e accessibile a livello globale.